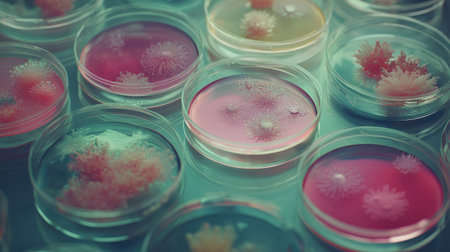
Multiple Petri dishes with various microorganism cultures on an organized lab surface, each with unique growths, symbolizing research diversity.の素材

素材 - Multiple Petri dishes with various microorganism cultures on an organized lab surface, each with unique growths, symbolizing research diversity.
作品情報
Multiple Petri dishes with various microorganism cultures on an organized lab surface, each with unique growths, symbolizing research diversity.
- ID:259917008
- 作品種別:
- 作者名:suphauarrn Manosri
キーワード
- acid
- analyzing
- aromatherapy
- arrangement
- backgrounds
- bacterium
- beauty
- beginnings
- beige
- biochemistry
- biology
- biotechnology
- body care
- botany
- care
- clean
- color image
- communication
- detox
- drop
- fungus
- green color
- growth
- handwriting
- healthcare and medicine
- healthy lifestyle
- high angle view
- horizontal
- indoors
- innovation
- laboratory
- microbiology
- no people
- one person
- people
- plant
- plastic
- research
- science
- scientist
- seed
- technology
- text
- thailand
- transparent
- tray
- virus
類似作品
A hand scrubs a...
many empty whit...
Dirty sink with...
Close-up of sta...
lots of dirty w...
stacks of color...
A beautifully o...
Stack of white ...
A kitchen count...
Lots of dirty d...
Plates layer on...
Dirty dishes in...
Stack of white ...
Bowls were stac...
white plates an...
Stack of colour...
Ceramic plates ...
Chaos Unleashed...
Wooden crockery...
drying dishes w...
Dirty dishes an...
A chef standing...
Rows of empty p...
lots of dirty w...
open dishwasher...
An overhead sho...
Rustic wooden s...
White ceramic p...
washed dishes i...
In a minimal ki...
Dishes are neat...
Big set of empt...
A kitchen fille...
A dishwasher wi...
A person standi...
Many colorful c...
Coffee cups arr...
A collection of...
Rustic kitchen ...
porcelain plate...
Rows and stacks...
shiny restauran...
Pile Of Plates ...
open dishwasher...
Clean dishes in...
Compulsive Hoar...
Set of Festive ...
Dishwasher afte...